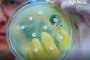
Откриха „суперактивен“ антибиотик 100 пъти по-силен от съществуващите

Президентът Ииияна Йотова за пореден път отрече да има отговорност за служебното правителство. Тя дари посочи резерви по отношение на определени министри. Тя изрази позицията си в кулоарите на парламента след края на клетвата на служебния...

Модерната медицина доказва, че ...
В забележителен медицински пробив ...

На 70 г. почина астроложката ...

Когато повечето хора мислят за ...

Физическият контакт е по-мощен, ...

Паметта не се състои само от факти ...

Любовта не е мистична или поетична, ...





Днес е денят на Прошката. Не е случайно, ...

бТВ Екшън 22 февруари 21:00ч.
Режисьор: Бър Стиърс (Burr Steers)
В ролите: Зак Ефрон Майк О'Донъл Матю Пери (Майк О'Донъл) Матю Пери Майк О'Донъл Лесли Ман (Скарлет) Лесли Ман Скарлет Томас Ленън (Нед) Томас Ленън
Във Фейсбук:
- Здравейте група! Пия билката шафран, но не знам за какво помага
Коментар:
- И аз пия ракия - без да знам за какво помага...от 36 години, най-редовно без да пропускам вечер...
Кметът Терзиев: "основен спонсор" на педофилите-рейнджъри от Петрохан според сайта им
Страницата “Хер Флик” тук е публикувала ...